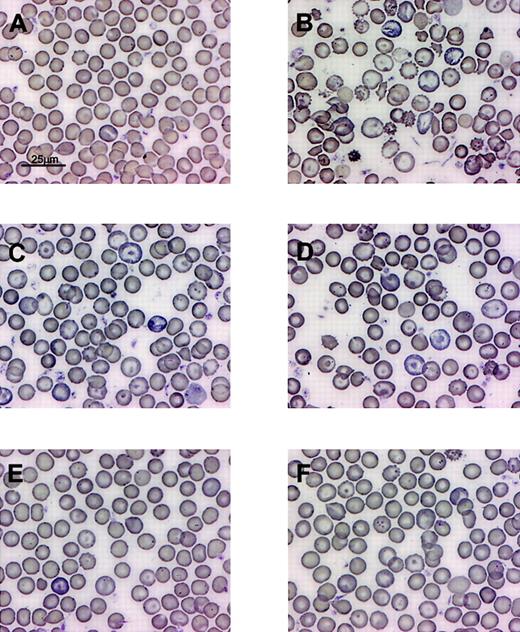
Fig. 6. The degree of correction of β-thalassemic red cell morphologic abnormalities correlates with the level of HbF resulting from lentiviral vector–encoded human γ-globin. / Wright-Giemsa–stained PB smears from (A) normal mouse, (B) mouse that received transplant of mock-transduced β-thalassemic BM cells, (C-F) mice that received transplants of γ-globin vector–transduced β-thalassemic BM cells and having HbF levels of 13%, 14%, 35%, and 16%.

Increased fetal hemoglobin (HbF) levels diminish the clinical severity of β-thalassemia and sickle cell anemia. A treatment strategy using autologous stem cell–targeted gene transfer of a γ-globin gene may therefore have therapeutic potential. We evaluated oncoretroviral- and lentiviral-based γ-globin vectors for expression in transduced erythroid cell lines. Compared with γ-globin, oncoretroviral vectors containing either a β-spectrin or β-globin promoter and the α-globin HS40 element, a γ-globin lentiviral vector utilizing the β-globin promoter and elements from the β-globin locus control region demonstrated a higher probability of expression. This lentiviral vector design was evaluated in lethally irradiated mice that received transplants of transduced bone marrow cells. Long-term, stable erythroid expression of human γ-globin was observed with levels of vector-encoded γ-globin mRNA ranging from 9% to 19% of total murine α-globin mRNA. The therapeutic efficacy of the vector was subsequently evaluated in a murine model of β-thalassemia intermedia. The majority of mice that underwent transplantation expressed significant levels of chimeric mα2hγ2molecules (termed HbF), the amount of which correlated with the degree of phenotypic improvement. A group of animals with a mean HbF level of 21% displayed a 2.5 g/dL (25 g/L) improvement in Hb concentration and normalization of erythrocyte morphology relative to control animals. γ-Globin expression and phenotypic improvement was variably lower in other animals due to differences in vector copy number and chromosomal position effects. These data establish the potential of using a γ-globin lentiviral vector for gene therapy of β-thalassemia.
Introduction
The hemoglobin disorders are highly prevalent, recessive genetic diseases in which coinheritance of 2 defective globin alleles results in severe hematologic disease. In patients with sickle cell anemia, the beta chain of hemoglobin S contains a substitution of valine for glutamic acid at position 6.1 This substitution results in a change in surface charge that predisposes deoxygenated HbS to polymerize, causing red cells to assume rigid sickled shapes leading to vaso-occlusion, painful crisis, and organ damage. Defective synthesis of β-globin in patients with severe β-thalassemia due to a variety of mutational mechanisms leads to the accumulation of aggregates of unpaired, insoluble α-chains that cause ineffective erythropoiesis, accelerated red cell destruction, and severe anemia.2 Although palliative therapies improve the quality and duration of life for many individuals, overall treatment for these disorders remains unsatisfactory. A few patients with sickle cell disease and a somewhat larger number with β-thalassemia have been cured with bone marrow (BM) transplantation from HLA-matched siblings, but such treatment is available for only a small minority of patients.3 4 These considerations have made the development of gene therapy for hemoglobin disorders a highly desired goal.
Effective gene therapy for hemoglobin disorders will require (1) relatively efficient gene transfer into repopulating, hematopoietic stem cells; (2) a method for achieving a substantial proportion (20% or greater) of genetically modified, autologous stem cells in patients without myeloablation; and (3) a globin vector configuration that predictably results in durable, high-level expression in differentiating erythroid cells after the gene therapy procedure. During the past few years, significant progress has been made in all 3 areas.
Initial success in genetic modification of repopulating stem cells from mice with murine oncoretroviral vectors was achieved in the early 1980s but extension of that success to large animal models and humans in early stage clinical trials has been highly problematic.5-8 More than a decade of focused effort to improve oncoretroviral gene transfer has resulted in levels of genetically modified cells of up to 5% to 20% in some but not all studied nonhuman primates and up to 5% to 10% in a few patients in recent human gene marking trials.9,10 Lentiviral vectors have inherent biologic advantages over murine oncoretroviral vector particles, and it is hoped that this will translate into improved stem cell gene transfer efficiency.11,12 Extensive experience using primitive human hematopoietic cells from cord blood and more limited experience with cytokine-mobilized cells from adult volunteers suggest that this system may provide improved gene transfer efficiency of repopulating stem cells.13-16
Several approaches have been explored for amplifying genetically modified stem cell populations by in vivo selection in order to obtain therapeutically relevant levels of corrected cells.17 A system based on a variant methylguanine, methyltransferase drug resistance gene in which temozolomide and O6-benzylguanine have been used for stem cell selection appears promising.18 The ability to dramatically amplify a minority population of genetically modified cells without limiting myelosuppression has allowed this system to be used to ameliorate the β-thalassemia phenotype with genetically modified and selected, normal stem cells in the absence of myeloablation (D.A.P. and B. Sorrentino, manuscript submitted).
In many respects, the most difficult aspect of developing gene therapy for the hemoglobin disorders has been to identify a vector genome configuration that sustains high-level, erythroid-specific gene expression in developing erythroblasts. In early studies, vectors that contained the β-globin gene driven by its own promoter were shown to transduce murine hematopoietic stem cells but globin gene expression was either absent or very low.19,20 Discovery of the locus control region (LCR) upstream of the human β-like globin gene locus initiated new efforts to make useful globin gene retroviral vectors.21,22 The functional elements from the LCR, detected as hypersensitive (HS) sites in nuclear chromatin, conferred high-level, relatively position-independent expression of globin genes in transgenic mice.23 However, incorporation of HS elements rendered oncoretroviral vectors unstable during passage in vitro or attempted transduction of primitive hematopoietic cells. Systematic elimination of cryptic splice and polyadenylation sites or empiric evaluation of the many potential orientations and order of individual HS sites yielded vectors that transferred a β-globin gene into primitive murine hematopoietic cells.24,25 These vectors failed to express therapeutic levels of globin and in some instances exhibited significant silencing over time.26 27
The goal of our studies was to derive a vector capable of high-level expression of the human γ-globin gene. Patients with either β-thalassemia or sickle cell genotypes display significant disease amelioration in the setting of increased fetal hemoglobin (HbF) levels.2 HbF (α2γ2) is a potent, natural antisickling hemoglobin in part because of formation of mixed tetramers, α2γβS, that do not participate in polymer formation.28 Furthermore, enhanced, vector-mediated expression of the γ-globin gene could improve β0-thalassemia without the risk of an immune response to the β-globin protein that might occur if it is expressed endogenously for the first time in the developing erythroblasts of these individuals. At the onset of this work, 3 potential approaches to direct vector-mediated γ-globin expression were emerging: (1) the use of alternative erythroid-specific promoters such as the β-spectrin or ankyrin promoters that do not depend on LCR elements29,30; (2) the use of the HS40 element from the α-globin locus, rather than LCR elements, to augment expression of alternative erythroid promoters or the β-globin promoter31,32; or (3) the use of optimized β-globin LCR elements to enhance expression of a β promoter–driven γ-globin gene. Recently, HIV-based lentiviral vectors have been shown to be capable of transferring complex genomes containing extended LCR elements linked to a β-globin gene.33 34 Phenotypic correction has been achieved in both β-thalassemia intermedia and sickle cell anemia murine models. Here we report the development of a novel self-inactivating, γ-globin lentiviral vector containing β-globin LCR elements that can direct therapeutic expression in a murine model of β-thalassemia intermedia. Our γ-globin lentiviral vector will provide an alternative therapeutic approach to the hemoglobin disorders based on increasing levels of HbF.
Materials and methods
Plasmid construction
Plasmids containing the various vector genomes were assembled using standard recombinant DNA technology. The details of all plasmid constructions are available upon request. The specific HS fragments used in the HS432β-Aγ vector have been previously described.35 A plasmid, AC553, containing the β-spectrin promoter was a gift from Dr D. Bodine (National Institutes of Health [NIH], Bethesda, MD).29 The 255-bp α-globin HS40 fragment was a gift from Dr G. Atweh (Mount Sinai Medical Center, New York, NY).31
Oncoretroviral and lentiviral vector preparation
VSV-G pseudotyped oncoretroviral vector particles were prepared using a 3-plasmid system (gene transfer vector plasmid, Gag/Pol plasmid, and VSV-G envelope plasmid) by transient transfection of 293T cells as previously described.36 Lentiviral vector particles were prepared as described previously, with some modifications.16 In brief, 293T cells were transfected with a mixture of plasmid DNA consisting of 6 μg pCAGkGP1R (Gag/Pol), 2 μg pCAG4-RTR2 (Rev/Tat), 2 μg pCAG-VSVG (VSV-G envelope), and 10 μg of gene transfer vector plasmid per 10-cm dish using the calcium phosphate precipitation technique. At 24 hours after transfection, the residual calcium-phosphate-DNA precipitate was removed by washing with 10 mL of phosphate-buffered saline (PBS). Serum-free X-VIVO 10 medium without phenol red (BioWhittaker, Walkersville, MD) was then added to each plate of cells. Then, 18 hours later, medium conditioned by vector-producing cells was harvested, cleared by low-speed centrifugation, and filtered through a 0.2-μm pore-sized cellulose acetate filter. In some cases, the conditioned medium was concentrated 100- to 200-fold by ultracentrifugation for 90 minutes at 25 000 rpm at 4°C using a Beckman Sw28 rotor (Beckman Instruments, Palo Alto, CA). Aliquots of vector preparations were quick frozen and kept at −80°C.
Titering of unconcentrated vector preparations was performed using NIH 3T3 cells and enumerating, by fluorescence-activated cell-sorter (FACS) analysis, the percentage of green fluorescent protein–positive (GFP+) cells derived by transduction with serial dilutions of conditioned media. For vectors not containing the GFP reporter, titers were determined by comparing the signal intensity of vector genome transfer into NIH 3T3 cells, as assessed by Southern blot analysis, relative to the signal obtained using CL10.1 murine stem cell virus (MSCV) GFP of known GFP titer.16
Culture and transduction of mouse erythroleukemia (MEL) cells
MEL cells were maintained in Dulbecco modified Eagle medium (DMEM) supplemented with 10% fetal bovine serum (FBS), 50 units/mL penicillin G, and 50 μg/mL streptomycin. In all experiments, transduction was performed by exposing 50 000 cells to a mixture of 1 mL viral supernatant (titer range of 1-5 × 105transducing units [TU]/mL) with 1 mL growth medium in the presence of polybrene at a final concentration of 6 μg/mL. Then, 24 hours later, vector-containing medium was replaced with fresh medium and cells were expanded. The GFP+ fraction was subsequently purified by flow cytometry and returned to culture. Erythroid induction was accomplished by adding 3 μMN,N′-hexamethylenebisacetamine and 10 μM hemin. Cells were harvested after 6 days and evaluated for γ-globin and GFP expression using the FACSCalibur (Becton Dickinson Immunocytochemistry Systems, San Jose, CA) as described in “FACS analysis of red cells for expression of human γ-globin” below. The data were analyzed using the Cell Quest System (Becton Dickinson Immunocytochemistry Systems).
Transduction and transplantation of murine BM cells
Mice heterozygous for the knocked-out β-major and β-minor globin gene locus and previously characterized as having a severe β-thalassemia phenotype that most closely represents human β-thalassemia intermedia were bred onto the HW80 background (histocompatible with C57Bl/6J mice) as previously described.37 38 BM cells from β-thalassemic or normal HW80 mice (B6.C-TyrcH1b Hbbd/By, Jackson Laboratory; Bar Harbor, MA) were harvested from the femurs and tibias 48 hours after treatment with 150 mg/kg 5-fluorouracil (Pharmacia; Kalamazoo, MI). Cells were placed into DMEM culture medium containing 20% FBS (Hyclone; Logan, UT) and 20 ng/mL murine interleukin-3 (IL-3), 50 ng/mL murine IL-6, 50 ng/mL murine stem cell factor (all obtained from R&D Systems, Minneapolis, MN). After 48 hours, cells were collected, washed with PBS, and 8 × 106 cells were pelleted and resuspended in 1.5 to 2.0 mL of concentrated vector (2-3 × 108 TU/mL) containing the above-stated concentration of serum/cytokines and polybrene at 6 μg/mL. This mixture was placed into a RetroNectin (TAKARA Shuzo, Otsu, Shiga, Japan)–coated (20 μg/cm2) 6-well plate and incubated at 37°C in a humidified incubator with 5% CO2. After 6 hours, additional growth medium (supplemented with cytokines and serum as above) was added to the culture to a final volume of 4 mL and the cells were further incubated overnight. The following day, cells were collected, washed with PBS, and resuspended in PBS containing 2% FCS. Lethally irradiated (1050 cGy) C57Bl/6J mice received transplants of 1 to 2 × 106 cells by tail-vein injection.
Hematologic analysis
Blood samples were obtained by retro-orbital puncture of anesthetized mice. Complete blood counts were obtained using an automated blood cell analyzer as previously described.38Peripheral blood (PB) films were prepared by standard methods. Hb cellulose acetate gel electrophoresis and quantitation of Hb bands was performed as previously described.38 An AlphaImager 2200 visualization system (Alpha Innotech, San Leandro, CA) was used to estimate the relative proportions of the Hb bands. “HbF” bands could not be accurately quantified below the 4% level and all animals in this category are referred to as less than 4% HbF mice. Reticulocyte counts were estimated as described by using flow cytometric analysis to determine the proportion of red cells staining with the RNA binding dye thiazole orange (Aldrich, Milwaukee, WI).39
FACS analysis of red cells for expression of human γ-globin
We used 5 to 10 μL of blood to fix, permeabilize, and stain red cells with a biotinylated monoclonal antibody against the human γ-globin chain (Perkin-Elmer Wallac, Norton, OH) as previously described.38 In brief, 5 μL of the monoclonal antibody was incubated for 30 minutes on ice with permeabilized cells. After washing, cells were then incubated in a 1:200 streptavidin–phycoerythrin (PE) secondary reagent (Southern Biotechnology, Birmingham, AL) in order to identify cells stained with the primary antibody. Red cells were gated on by light scatter characteristics and analyzed for PE fluorescence using a FACSCalibur.
Ribonuclease protection assay
Preparation of RNA from PB samples was done using Rnazol B (Tel-Test; Friendswood, TX) according to the manufacturer's specifications. Determination of human γ-globin and murine α-globin mRNA levels as assessed by the relative amounts of their respective exon 2 protected fragments was performed using an RPAII RNase protection assay kit as described previously according to the manufacturer's specifications.38 In the current studies, a riboprobe containing both antisense human Aγ-globin and murine α-globin sequences was used (gift from Dr D. Bodine).40 This riboprobe is characterized by having equal specific activities of the human Aγ-globin and murine α-globin sequences, thereby allowing a direct comparison ofAγ-globin and α-globin mRNA levels. The relative level of lentiviral vector–encoded human Aγ-globin mRNA compared with endogenous murine α-globin mRNA was determined by dividing the signal of the human Aγ-globin protected fragment by the value of the signal of the murine α-globin protected fragment. To normalize expression per vector copy relative to an endogenous α-globin gene, this value was further divided by the estimated vector copy number and multiplied by a factor of 4 to correct for the number of α-globin genes. A Molecular Dynamics (Sunnyvale, CA) Storm Phosphoimager and its accompanying software were used to visualize and quantitate the protected fragments.
DNA analysis
MEL cell, PB leukocyte (PBL), BM, and spleen colony DNA samples were prepared, digested with the restriction enzymes, and subjected to Southern blot analysis as previously described.38 XmaI was used to liberate full-length oncoretroviral proviral fragments. The enzyme BglII, which cuts at the ends of the provirus and liberates a near unit length provirus, and enzymeKpnI, which cuts once within the provirus, were used to verify the presence of unrearranged lentiviral vector and determine the number of vector integrations, respectively. A radiolabeled GFP or viral rev-responsive element (RRE) DNA probe was hybridized with the blot and the resulting hybridizing bands were visualized and quantitated using the Molecular Dynamics Storm Phosphoimager and its accompanying software.
Determination of average vector copy number by semiquantitative polymerase chain reaction (PCR)
Semiquantitative PCR was performed on the PBL genomic DNA of β-thalassemic mice that received transplants of BM transduced with the γ-globin vectors. The standard samples were prepared by making dilutions of DNA from a MEL cell line containing a single, integrated copy of the d432β-Αγ MSCV GFP provirus into mouse spleen DNA. This MEL cell clone also contains only one copy of the mouse β-major gene due to monosomy 7 (data not shown). Standards included a range of copy number from 0.05 to 1.0. The signal from mouse β-major was used as a loading control. Duplex PCR (25 cycles) was performed using an MJ Research PTC-200 peltier thermocycler (Watertown, MA). Primers were as follows: 5′ mouse β-major primer 5′-cctatcctctgcctctgcta-3′ and 3′ primer 5′-cttctggaaggcagcctgtg-3′; 5′ γ-globin primer 5′-agcaacctcaaacagacacc-3′ and 3′ primer 5′-ggccactccagtcaccatctt-3′. DNA template (250 ng) was used and the reaction mixture contained 32P-labeled deoxycytidine 5′-triphosphate (dCTP) (ICN, Irvine, CA) to label the amplified products. A Molecular Dynamics Storm Phosphorimager was used to quantitate the signals of the amplified products and the vector copy number was calculated by comparing the γ/β ratio of the unknown sample to the γ/β ratio of the standards of known copy number using standard linear regression analysis.
Spleen colony-forming unit (CFU-S) assay
BM cells (0.5-1.0 × 105) from mice receiving primary transplantations were transplanted into normal C57Bl/6J mice pretreated with 900 cGy irradiation. At 13 days following transplantation, mice were killed and well-separated, discrete splenic colonies were carefully dissected and a single cell suspension was prepared. A portion of the cells was used to prepare genomic DNA for determination of vector copy number, as described in “DNA analysis” above, while the rest of the sample was subjected to fixation, permeabilization, and staining with the TER119-PE antibody, which recognizes erythroid cells, and a fluorescein isothiocyanate (FITC)–labeled antibody against human γ-globin. The cells were analyzed using a FACSCalibur.
Statistical analysis
The probability of a statistically significant difference between the mean values of 2 data sets was determined by a 2-tailed Student t test using InStat 2.03 software from Apple Computers (Cupertino, CA).
Results
Evaluation of γ-globin oncoretroviral and lentiviral vectors
Initially, we sought to develop an oncoretroviral vector utilizing an erythroid promoter coupled with the HS40 enhancer from the α-globin locus.41 The β-spectrin promoter, which directs high-level expression of the β-spectrin cytoskeletal protein in developing erythroblasts,29,42 and a 130-bp β-globin promoter were chosen for testing. γ-Globin expression cassettes utilizing these promoters coupled with the upstream HS40 enhancer were placed in an MSCV-based oncoretroviral vector. These constructs were also designed to express the GFP marker under the transcriptional control of the viral long terminal repeat (LTR) (Figure1A; MSCV-GFP HS40 βspectrinAγ and MSCV-GFP HS40βglobin Aγ).43 44 Vector particles were derived for both constructs (4-5 × 105 IU/mL) and used to transduce MEL cells. A pool of GFP+ cells for each vector was then isolated for study. Southern blot analysis demonstrated unrearranged transfer of both vector genomes (Figure 1B). γ-Globin expression in each pool was then assessed by FACS analysis following induction to terminal erythroid differentiation. Despite having a 2-fold lower average vector copy number (Figure 1B), the cell pool transduced with the MSCV-GFP HS40 βglobin Aγ vector consistently demonstrated a much higher proportion of γ-globin–expressing cells than the MSCV-GFP HS40 βspectrinAγ–transduced cell pool (Figure1C, top panel). However, the majority of transduced cells failed to express the globin cassette, suggesting that expression of both globin vectors suffered, in varying degrees, from significant position effects. This interpretation was verified by the observation that individual GFP+ clones from the MSCV-GFP HS40βglobinAγ–transduced cell population also variably expressed γ-globin (data not shown). To ascertain whether a potentially stronger enhancer might alleviate the position effects we observed with these vectors, the HS40 element was replaced with DNA fragments from the β-globin LCR consisting of HS sites 4 (756 bp), 3 (898 bp), and 2 (374 bp) (MSCV-GFP HS432 βglobin Aγ; Figure 1A). However, as we and others have observed in the past, the LCR-containing vector was produced at extremely low titer (< 102 TU/mL), precluding evaluation of this design.
Improved γ-globin vector expression using β-globin LCR elements in a lentiviral vector backbone.
(A) Schematic representations of oncoretroviral- and lentiviral-based γ-globin vectors. MSCV-based oncoretroviral vectors express GFP from the viral LTR and contain the different Aγ-globin cassettes in reverse orientation. The β-spectrin (−576) and β-globin promoters (−130), along with their respective 5′ untranslated sequences, were fused to the Aγ-globin coding sequence at position −3 and +1 relative to the endogenous translational start site. A 255-bp fragment containing the α-globin HS40 enhancer element was placed adjacent to the promoters. The same β-globin promoter, γ-globin coding sequences, and 3′ untranslated and downstream sequences (466 bp) were also placed downstream of β-globin LCR elements containing sites HS4 (756 bp), HS3 (898 bp), and HS2 (374 bp) in both oncoretroviral and HIV-based lentiviral vector backbones. The γ-globin gene contained a 720-bp deletion in the second intron in all of the vectors. The lentiviral vector HS432 β-Aγ MSCV-GFP also contained an MSCV LTR-driven GFP cassette. The GFP cassette was removed to yield HS432β-Aγ. d432β-Aγ contained a 311-bp deletion in HS4 outside of the “core” element. The β-globin enhancer (β 3′ Enh) or the γ-globin 3′ regulatory element (γ 3′ RE) was placed downstream of the γ-globin coding sequences to derive 2 additional lentiviral vectors. (B) Southern blot analysis, using a radiolabeled GFP probe, of DNA from MEL cells transduced with the oncoretroviral vectors MSCV-GFP HS40βspectrinAγ and MSCV-GFP HS40βglobinAγ and the lentiviral vector HS432β-Aγ MSCV-GFP. DNA (10 μg) from each GFP+ MEL cell pool was digested to release a full- or near full–length proviral fragment. The respective plasmid DNAs for each construct were concurrently digested and run as controls for correct molecular size. (C) FACS analysis for γ-globin expression (PE fluorescence) following erythroid induction of MEL cells transduced with vectors containing the γ-globin expression cassette driven by the 5′ regulatory elements as indicated above each dot plot. The top row of dot plots shows representative results from 2 independent experiments comparing the 2 HS40-based oncoretroviral vectors. The bottom 2 dot plots are representative results from 3 independent experiments comparing the oncoretroviral-based HS40/β-globin promoter vector and lentiviral-based HS432/β-globin promoter vector. The percentage of γ-globin–positive cells relative to all transduced, GFP+ cells is indicated for each dot plot. MEL cells transduced with a vector encoding only GFP failed to show staining for γ-globin (data not shown).
Improved γ-globin vector expression using β-globin LCR elements in a lentiviral vector backbone.
(A) Schematic representations of oncoretroviral- and lentiviral-based γ-globin vectors. MSCV-based oncoretroviral vectors express GFP from the viral LTR and contain the different Aγ-globin cassettes in reverse orientation. The β-spectrin (−576) and β-globin promoters (−130), along with their respective 5′ untranslated sequences, were fused to the Aγ-globin coding sequence at position −3 and +1 relative to the endogenous translational start site. A 255-bp fragment containing the α-globin HS40 enhancer element was placed adjacent to the promoters. The same β-globin promoter, γ-globin coding sequences, and 3′ untranslated and downstream sequences (466 bp) were also placed downstream of β-globin LCR elements containing sites HS4 (756 bp), HS3 (898 bp), and HS2 (374 bp) in both oncoretroviral and HIV-based lentiviral vector backbones. The γ-globin gene contained a 720-bp deletion in the second intron in all of the vectors. The lentiviral vector HS432 β-Aγ MSCV-GFP also contained an MSCV LTR-driven GFP cassette. The GFP cassette was removed to yield HS432β-Aγ. d432β-Aγ contained a 311-bp deletion in HS4 outside of the “core” element. The β-globin enhancer (β 3′ Enh) or the γ-globin 3′ regulatory element (γ 3′ RE) was placed downstream of the γ-globin coding sequences to derive 2 additional lentiviral vectors. (B) Southern blot analysis, using a radiolabeled GFP probe, of DNA from MEL cells transduced with the oncoretroviral vectors MSCV-GFP HS40βspectrinAγ and MSCV-GFP HS40βglobinAγ and the lentiviral vector HS432β-Aγ MSCV-GFP. DNA (10 μg) from each GFP+ MEL cell pool was digested to release a full- or near full–length proviral fragment. The respective plasmid DNAs for each construct were concurrently digested and run as controls for correct molecular size. (C) FACS analysis for γ-globin expression (PE fluorescence) following erythroid induction of MEL cells transduced with vectors containing the γ-globin expression cassette driven by the 5′ regulatory elements as indicated above each dot plot. The top row of dot plots shows representative results from 2 independent experiments comparing the 2 HS40-based oncoretroviral vectors. The bottom 2 dot plots are representative results from 3 independent experiments comparing the oncoretroviral-based HS40/β-globin promoter vector and lentiviral-based HS432/β-globin promoter vector. The percentage of γ-globin–positive cells relative to all transduced, GFP+ cells is indicated for each dot plot. MEL cells transduced with a vector encoding only GFP failed to show staining for γ-globin (data not shown).
Over the course of these studies, we developed an HIV-based lentiviral vector system that includes a self-inactivating gene transfer vector backbone and distribution of the packaging functions (Gag/Pol, Rev/Tat, and envelope) among 3 separate plasmids.16 The HS432βglobinAγ assembly contained in the above-described oncoretroviral vector was placed into the lentiviral backbone that also contained an MSCV-driven GFP reporter (HS432β-Aγ MSCV-GFP; Figure 1A). In contrast to the poor titer observed with the corresponding oncoretroviral vector MSCV-GFP HS432βglobinAγ, VSV-G–pseudotyped preparations of the γ-globin lentiviral vector had titers of about 0.5-1.0 × 105 TU/mL. The vector genome was transferred unrearranged into MEL cells (Figure 1B). We consistently observed a substantially greater fraction of GFP+ MEL cells expressing the γ-globin lentiviral vector compared with cells with a similar vector copy number transduced with the HS40 β-promoter γ-globin oncoretroviral vector (Figure 1C, lower panel). Correspondingly, γ-globin mRNA levels were higher in the cells transduced with the lentiviral vector (9% of endogenous murine α-globin vs 5%).
Human γ-globin gene expression in murine erythrocytes following lentiviral-mediated stem cell gene transfer
To test the γ-globin lentiviral vector in vivo, a vector lacking the MSCV-GFP cassette was generated (HS432β-Aγ; Figure1A). The titer of the resulting, single gene γ-globin vector was 5- to 10-fold higher (0.5 to 1.0 × 106 TU/mL) than the vector containing the GFP reporter, as assessed by Southern blot analysis of genome transfer to NIH 3T3 cells (data not shown). However, Northern blot analysis of RNA from 293T cells producing the single gene vector indicated the presence of a significant amount of a truncated viral genomic transcript corresponding to a potential premature polyadenylation occurring within the HS4 element (data not shown). A 3′ rapid analysis of cDNA ends (RACE) analysis confirmed premature polyadenylation occurring within the HS4 element (H.H., unpublished observations, March 2001). This site was deleted from the HS4 element (reducing its size from 756 bp to 445 bp) in the vector plasmid (yielding d432β-Aγ) and resulted in a further improvement in titer to approximately 3 to 5 × 106TU/mL. Addition of either the 3′ β-enhancer (β 3′ Enh) element45 or a 3′ regulatory element of theAγ-globin gene (γ 3′ RE),46 both located downstream from the respective endogenous genes, was made separately to this vector to potentially improve γ-globin expression (Figure 1A). All 3 vectors were of similar titer and were transmitted without rearrangement to NIH 3T3 target cells (Figure2 and data not shown).
Unrearranged d432β-Αγ 3′RE vector is present in the genomic DNA from PB leukocytes and spleen cells of animals 32 weeks following transplantation with vector-transduced BM cells.
Southern blot analysis, using a 32-P labeled RRE probe, of the indicated genomic DNA digested with BglII. This enzyme cuts once in the 5′ LTR and immediately inside the 3′ LTR of the integrated d432β-Aγ 3′RE vector (Figure 1A), thereby liberating a near unit length proviral form. DNA samples are as follows: (plasmid) d432β-Aγ 3′RE vector plasmid DNA mixed with genomic NIH3T3 DNA; (NIH3T3) NIH3T3 cells transduced with the d432β-Aγ 3′RE vector; (Neg) naive NIH 3T3 cells; (1 copy) MEL cells harboring a single copy of d432β-Aγ MSCV GFP (BglII digestion liberates a subgenomic vector fragment); PB, and (Spl) spleen of the indicated mice. Genomic DNA (15 μg) was used in all cases except for the PB lanes, which contained 5 μg. The arrow indicates a 7.2-kb hybridizing fragment, which is of the correct predicted size of an integrated, unrearranged d432β-Aγ 3′RE provirus.
Unrearranged d432β-Αγ 3′RE vector is present in the genomic DNA from PB leukocytes and spleen cells of animals 32 weeks following transplantation with vector-transduced BM cells.
Southern blot analysis, using a 32-P labeled RRE probe, of the indicated genomic DNA digested with BglII. This enzyme cuts once in the 5′ LTR and immediately inside the 3′ LTR of the integrated d432β-Aγ 3′RE vector (Figure 1A), thereby liberating a near unit length proviral form. DNA samples are as follows: (plasmid) d432β-Aγ 3′RE vector plasmid DNA mixed with genomic NIH3T3 DNA; (NIH3T3) NIH3T3 cells transduced with the d432β-Aγ 3′RE vector; (Neg) naive NIH 3T3 cells; (1 copy) MEL cells harboring a single copy of d432β-Aγ MSCV GFP (BglII digestion liberates a subgenomic vector fragment); PB, and (Spl) spleen of the indicated mice. Genomic DNA (15 μg) was used in all cases except for the PB lanes, which contained 5 μg. The arrow indicates a 7.2-kb hybridizing fragment, which is of the correct predicted size of an integrated, unrearranged d432β-Aγ 3′RE provirus.
Normal murine BM cells were transduced with the d432β-Aγ 3′RE vector and transplanted into lethally irradiated normal C57Bl/6J mice. Flow cytometric analysis 17 weeks after transplantation demonstrated pancellular expression of γ-globin in PB red cells (Figure 3A). The pattern and level of γ-globin expression was stable out to 32 weeks after transplantation (data not shown). Human γ-globin mRNA expression was documented by a ribonuclease protection assay (Figure 3B) at levels ranging from 9% to 19% (mean, 11.8% ± 2.4%) of the level of total mouse α-globin mRNA. This translated to a level of 12% to 25% (mean, 15.7% ± 3.2%) per vector copy per copy of α-globin. Southern blot analysis of DNA obtained from PB and spleen cells from 2 representative animals demonstrated the presence of a hybridizing band of the correct molecular size of the unrearranged provirus (Figure 2). Compared with the band intensity of a cell line containing a single copy of an integrated lentivirus, the average vector copy number, when adjusted for the amount of DNA loaded, in the PB and spleen of these mice was approximately 3. These data established the functionality of this vector in vivo and led us to evaluate its potential for correcting the phenotype of animals with β-thalassemia intermedia.
Human Aγ-globin expression in normal murine red cells.
(A) FACS analysis for human γ-globin expression (HbF-PE fluorescence) in the red cells of normal mice 17 weeks following transplantation with normal BM cells transduced with the d432β-Aγ 3′RE lentiviral vector. Shown at top is a histogram for γ-globin expression (solid lines) in the red cells of a β-thalassemic mouse harboring 2 copies of a β-spectrin promoter-driven γ-globin transgene (THAL 2γ). Below are histograms for γ-globin expression in the red cells of mice that underwent transplantation (mouse number indicated at right). The dotted line indicates the staining profile of red cells from a control mouse that did not undergo transplantation. (B) RNase protection analysis for the levels of vector-encodedAγ-globin and endogenous murine α-globin mRNAs. RNA (0.25 μg) from reticulocytes of the mice indicated above each lane was hybridized to a 32P-labeled antisense riboprobe that protects both exon 2 of the γ-globin gene and exon 2 of the murine α-globin gene. The relative γ/α ratio, indicated below each lane, was obtained by dividing the γ-globin signal (hγ) by the α-globin signal (mα). Neg indicates negative control mouse; Tg, sample from the above-described β-thalassemic/γ-globin transgenic mouse.
Human Aγ-globin expression in normal murine red cells.
(A) FACS analysis for human γ-globin expression (HbF-PE fluorescence) in the red cells of normal mice 17 weeks following transplantation with normal BM cells transduced with the d432β-Aγ 3′RE lentiviral vector. Shown at top is a histogram for γ-globin expression (solid lines) in the red cells of a β-thalassemic mouse harboring 2 copies of a β-spectrin promoter-driven γ-globin transgene (THAL 2γ). Below are histograms for γ-globin expression in the red cells of mice that underwent transplantation (mouse number indicated at right). The dotted line indicates the staining profile of red cells from a control mouse that did not undergo transplantation. (B) RNase protection analysis for the levels of vector-encodedAγ-globin and endogenous murine α-globin mRNAs. RNA (0.25 μg) from reticulocytes of the mice indicated above each lane was hybridized to a 32P-labeled antisense riboprobe that protects both exon 2 of the γ-globin gene and exon 2 of the murine α-globin gene. The relative γ/α ratio, indicated below each lane, was obtained by dividing the γ-globin signal (hγ) by the α-globin signal (mα). Neg indicates negative control mouse; Tg, sample from the above-described β-thalassemic/γ-globin transgenic mouse.
Phenotypic correction of murine β-thalassemia intermedia following lentiviral-mediated transfer of a human γ-globin gene
These experiments were initially designed to compare the expression and therapeutic efficacy of the d432β-Aγ vector and 2 modified versions containing either the regulatory element downstream from the Aγ-globin gene (γ 3′ RE) or the enhancer from downstream of the human β-globin gene (β 3′ Enh; Figure 1A). Because β-thalassemic mice are somewhat limited in availability and we wished to obtain a significant number of recipient mice for study of the different vectors, we transplanted β-thalassemic BM cells transduced with the various vectors into lethally irradiated, normal C57Bl/6J mice. We have previously shown that normal recipients of β-thalassemic BM acquire the β-thalassemic phenotype following hematologic reconstitution.38 In addition to these 3 vector cohorts, 2 control cohorts of mice received transplants of either mock-transduced β-thalassemic BM cells or normal BM cells transduced with a lentiviral vector encoding only GFP.
At 15 weeks following transplantation, PB was obtained from the mice that underwent transplantation, and the hematologic parameters and red cell γ-globin expression were evaluated. Complete hematologic reconstitution with the donor graft occurred in all recipient mice as verified by the absence on Hb electrophoresis analysis of the endogenous “single” Hb phenotype (data not shown). In an initial analysis, the average level of γ-globin production, as reflected by the mean fluorescence intensity (MFI) of γ-globin–positive red cells, did not significantly vary among the 3 groups of animals receiving cells transduced with 1 of the 3 γ-globin vectors (data not shown). Accordingly, subsequent data analysis encompassed all of the mice that received transplants of γ-globin–transduced β-thalassemic cells in order to better evaluate the impact of the level of γ-globin gene expression on the degree of correction of the thalassemic phenotype. All 21 mice that received γ-globin vector–transduced cells displayed γ-globin–positive red cells (range, 7%-90%), as judged by FACS analysis. The majority of the animals displayed expression in more than 40% of their red cells with a concomitant improvement in hematologic parameters (Figure4A and Table1). Significant amounts of chimeric mα2hγ2 hemoglobin molecules (termed HbF) were observed in the red cell lysates from these animals that underwent transplantation as assessed by cellulose acetate electrophoresis (Figure 4B). Densitometric scanning of the cellulose acetate gels allowed estimation of the percent HbF relative to that of the endogenous mouse hemoglobin molecules. The PB content of HbF constituted more than 10% of the total hemoglobin in 14 of 21 animals.
Lentiviral vector-mediated human Aγ-globin expression in erythrocytes derived from transplanted, β-thalassemic repopulating cells transduced with the d432-β-Aγ lentiviral vectors.
(A) FACS analysis for human Aγ-globin expression (HbF-PE fluorescence) in β-thalassemic red cells 15 weeks following transplantation with γ-globin vector-transduced β-thalassemic BM cells. At top is the histogram from the β-thalassemic/γ-globin transgenic control animal. Below are histograms of γ-globin expression from representative mice (mouse numbers indicated) that received transplants of genetically modified cells (solid lines). The percentage of red cells with unequivocal γ-globin expression is shown at the right of each histogram along with the average PBL vector copy (VC) number. The dotted line indicates the staining profile of red cells from a mouse that received transplants of mock-transduced β-thalassemic BM cells. (B) Cellulose acetate Hb electrophoresis gels were used to separate the different Hb species of red cell lysates as indicated by the arrow to the right. This β-thalassemic mouse strain has the “diffuse” Hb pattern characterized by an uppermost mα2mβ species and a faster migrating mα2β species. Chimeric mα2hγ2 molecules migrate faster than the endogenous murine Hb species as demonstrated in the β-thalassemic/γ-globin transgenic mouse lane (Tg). No endogenous murine “single” Hb molecules, which migrate between the “diffuse” and chimeric species, were observed, indicating full donor engraftment. M indicates mouse that received transplants of mock-transduced β-thalassemic BM cells; numbered lanes represent samples from representative mice that received transplants of γ-globin vector-transduced β-thalassemic BM cells. % F indicates the quantity of the chimeric mα2hγ2species, estimated by densitometry, as a proportion of all Hb species. % F cells indicates the proportion of red cells staining for human γ-globin by FACS analysis. Vector copy number is the average copy number in PBLs as estimated by DNA PCR. For reference, the uppermost mα2mβ band makes up approximately 20% of total mouse Hb.
Lentiviral vector-mediated human Aγ-globin expression in erythrocytes derived from transplanted, β-thalassemic repopulating cells transduced with the d432-β-Aγ lentiviral vectors.
(A) FACS analysis for human Aγ-globin expression (HbF-PE fluorescence) in β-thalassemic red cells 15 weeks following transplantation with γ-globin vector-transduced β-thalassemic BM cells. At top is the histogram from the β-thalassemic/γ-globin transgenic control animal. Below are histograms of γ-globin expression from representative mice (mouse numbers indicated) that received transplants of genetically modified cells (solid lines). The percentage of red cells with unequivocal γ-globin expression is shown at the right of each histogram along with the average PBL vector copy (VC) number. The dotted line indicates the staining profile of red cells from a mouse that received transplants of mock-transduced β-thalassemic BM cells. (B) Cellulose acetate Hb electrophoresis gels were used to separate the different Hb species of red cell lysates as indicated by the arrow to the right. This β-thalassemic mouse strain has the “diffuse” Hb pattern characterized by an uppermost mα2mβ species and a faster migrating mα2β species. Chimeric mα2hγ2 molecules migrate faster than the endogenous murine Hb species as demonstrated in the β-thalassemic/γ-globin transgenic mouse lane (Tg). No endogenous murine “single” Hb molecules, which migrate between the “diffuse” and chimeric species, were observed, indicating full donor engraftment. M indicates mouse that received transplants of mock-transduced β-thalassemic BM cells; numbered lanes represent samples from representative mice that received transplants of γ-globin vector-transduced β-thalassemic BM cells. % F indicates the quantity of the chimeric mα2hγ2species, estimated by densitometry, as a proportion of all Hb species. % F cells indicates the proportion of red cells staining for human γ-globin by FACS analysis. Vector copy number is the average copy number in PBLs as estimated by DNA PCR. For reference, the uppermost mα2mβ band makes up approximately 20% of total mouse Hb.
The degree of correction of the β-thalassemic phenotype correlated closely with the total level of HbF (Figure5). The hematologic characteristics of all of the animals, after grouping according to the observed level of HbF, are shown in Table 1. As we have previously observed, animals that received transplants of mock-transduced β-thalassemic BM cells accurately reproduced the β-thalassemic phenotype (Figures 5B,6, and Table 1). Animals with HbF levels ranging from 10% to 15% (mean, 12.6%) exhibited a 1 g/dL (10 g/L) improvement in Hb concentration, whereas animals having total HbF levels of greater than 15% (mean, 20.8%) displayed nearly complete hematologic correction with a 2.5 g/dL (25 g/L) increase in Hb level. Animals that received transplants of γ-globin vector–transduced BM cells and having less than 4% HbF had minimal improvement in Hb concentration compared with control animals that received transplants of mock-transduced β-thalassemic BM cells. The degree of correction of red cell indices, reticulocyte count, and red cell morphologic abnormalities also correlated with the level of HbF (Table 1 and Figure 6).
The degree of amelioration of the anemia of β-thalassemia correlates with the level of HbF resulting from lentiviral vector–encoded human γ-globin.
(A) Hb concentration versus HbF in animals that received transplants of β-thalassemic BM cells transduced with γ-globin lentiviral vectors. Animals with less than 4% HbF were excluded from the analysis because the levels of HbF could not be accurately determined below this level. Linear regression analysis was used to generate the trend line, which had a correlation coefficient (r2) of 0.80. (B) Hb concentration is shown as a function of the mean level of HbF in the designated groups of animals that underwent transplantation. Mock indicates animals transplanted with mock-transduced β-thalassemic BM cells; normal control, animals that received transplants of normal BM cells transduced with a lentiviral vector, CL10.1 MSCV-GFP, that encodes only GFP. Error bars represent the standard error of the mean.
The degree of amelioration of the anemia of β-thalassemia correlates with the level of HbF resulting from lentiviral vector–encoded human γ-globin.
(A) Hb concentration versus HbF in animals that received transplants of β-thalassemic BM cells transduced with γ-globin lentiviral vectors. Animals with less than 4% HbF were excluded from the analysis because the levels of HbF could not be accurately determined below this level. Linear regression analysis was used to generate the trend line, which had a correlation coefficient (r2) of 0.80. (B) Hb concentration is shown as a function of the mean level of HbF in the designated groups of animals that underwent transplantation. Mock indicates animals transplanted with mock-transduced β-thalassemic BM cells; normal control, animals that received transplants of normal BM cells transduced with a lentiviral vector, CL10.1 MSCV-GFP, that encodes only GFP. Error bars represent the standard error of the mean.
The degree of correction of β-thalassemic red cell morphologic abnormalities correlates with the level of HbF resulting from lentiviral vector–encoded human γ-globin.
Wright-Giemsa–stained PB smears from (A) normal mouse, (B) mouse that received transplant of mock-transduced β-thalassemic BM cells, (C-F) mice that received transplants of γ-globin vector–transduced β-thalassemic BM cells and having HbF levels of 13%, 14%, 35%, and 16%.
The degree of correction of β-thalassemic red cell morphologic abnormalities correlates with the level of HbF resulting from lentiviral vector–encoded human γ-globin.
Wright-Giemsa–stained PB smears from (A) normal mouse, (B) mouse that received transplant of mock-transduced β-thalassemic BM cells, (C-F) mice that received transplants of γ-globin vector–transduced β-thalassemic BM cells and having HbF levels of 13%, 14%, 35%, and 16%.
The average vector copy number in the PBL of the individual mice was estimated by semiquantitative DNA PCR and used to obtain the mean vector copy value for each of the designated groups of animals (Table1). For the groups, in general, a higher vector copy number was associated with a higher level of F cells, HbF, and degree of phenotypic improvement. However, there was not a high degree of correlation (r2 = 0.47) between the average vector copy number and the proportion of F cells for individual mice (Figures 7A, 4A), suggesting copy number–related rather than copy number–dependent vector expression. In addition, although there was no statistically significant difference in the mean average copy numbers of the 10% to 15% F versus the more than 15% F groups, there was a difference in the number of F cells and the HbF level. These data suggested that vector integration sites significantly influenced the degree of γ-globin vector expression.
Position effects lead to variable globin vector expression in vivo.
(A) Percent F cells versus average PBL vector copy number in animals that received transplants of β-thalassemic BM cells transduced with γ-globin lentiviral vectors. Although γ-globin expression is vector copy–related, linear regression analysis showed a correlation coefficient (r2) of 0.47, indicating some variability in correlation. Some animals with similar vector copy numbers show large differences in the proportion of expressing cells. (B) FACS analysis of γ-globin expression in PB red cells and in TER119-positive, clonal erythroid cells derived from secondary CFU-Ss of 2 animals that received transplants of globin vector transduced β-thalassemic BM cells. Top panels show γ-globin expression (solid lines) in the red cells of animals no. 21 and no. 24, with histograms of γ-globin expression (solid lines) in unique, clonal erythroid cells of each animal shown below. The number of vector copies present in each clone, as determined by Southern blot analysis, is indicated. Dotted lines in the histograms represent staining of a negative control sample.
Position effects lead to variable globin vector expression in vivo.
(A) Percent F cells versus average PBL vector copy number in animals that received transplants of β-thalassemic BM cells transduced with γ-globin lentiviral vectors. Although γ-globin expression is vector copy–related, linear regression analysis showed a correlation coefficient (r2) of 0.47, indicating some variability in correlation. Some animals with similar vector copy numbers show large differences in the proportion of expressing cells. (B) FACS analysis of γ-globin expression in PB red cells and in TER119-positive, clonal erythroid cells derived from secondary CFU-Ss of 2 animals that received transplants of globin vector transduced β-thalassemic BM cells. Top panels show γ-globin expression (solid lines) in the red cells of animals no. 21 and no. 24, with histograms of γ-globin expression (solid lines) in unique, clonal erythroid cells of each animal shown below. The number of vector copies present in each clone, as determined by Southern blot analysis, is indicated. Dotted lines in the histograms represent staining of a negative control sample.
Position effects on γ-globin vector expression in clonal CFU-S erythroid cells
In order to confirm that position effects were contributing to poor vector expression in some instances, 2 animals with different levels of γ-globin expression in PB red cells (Figure 7B, top panels), but with a similar average PBL vector copy number (approximately 1.5) at the time of death, were killed and their BM cells were transplanted into secondary normal recipients. Southern blot analysis confirmed the presence of unrearranged provirus in the BM cells of both donors (data not shown). At 13 days after transplantation, clonal splenic colonies derived from primitive CFU-S cells were obtained and TER119-positive erythroblasts were assessed for γ-globin expression by FACS analysis. In addition, the presence and number of vector integrations for each clone was determined by Southern blot analysis (data not shown). Identified from animal no. 21 were 6 vector DNA–positive clones, consisting of 4 unique clones, having either 1 or 2 vector copies. All clones displayed poor vector expression, similar to that observed in the red cells of the donor (Figure 7B, left panel; and data not shown). However, for animal no. 24, one unique 2–vector copy clone (24-39) was identified that demonstrated high-level staining for γ-globin (Figure 7B, right panel). This particular clone was predominant in animal no. 24 and constituted the majority of vector DNA–positive CFU-S clones (15/18 colonies). This is consistent with the apparent substantial contribution of this clone to the PB red cells of donor animal no. 24. These data are also consistent with the amount of chimeric Hb molecules observed in the PB of the donor animals no. 21 (undetectable) and no. 24 (12% F). These results verify that progenitor clones with 1 or 2 unique vector integrations display a range of different expression patterns in their erythroid progeny (compare clones 21-6 and 24-18; clones 21-3 and 24-39), indicating chromosomal position effects on vector expression.
Discussion
Our results show that lentiviral-mediated gene transfer of a human γ-globin expression cassette containing HS elements from the β-globin LCR can result in both substantial expression of γ-globin and improvement of murine β-thalassemia intermedia. The degree of phenotypic correction relative to the total level of chimeric mα2hγ2 molecules (HbF) in the current study compares favorably to that which we previously observed in β-thalassemic animals expressing human γ-globin transgenes.38 Our results are also consistent with those reported by May et al using a β-globin lentiviral vector that yielded a total level of mα2hβ2 molecules of 21% and a 3.0 g/dL (30 g/L) increase in Hb concentration 15 weeks following transplantation of transduced cells from a similar strain of β-thalassemic mice.33 Although our vector achieved levels of normalized globin mRNA per vector copy (about 16%) and chimeric Hb molecules (about 21% of total Hb) comparable to that reported by May et al,33 a higher vector copy than reported in their study (2.4 vs 0.8) was needed to achieve these results. This likely reflects an overall stronger transcriptional activity from the larger LCR configuration (total of 3.2 kb) and β-globin promoter (approximately 600 bp) used in their vector compared with the smaller corresponding elements contained in our vector. However, that study examined a relatively small number of mice, and vector performance may be more variable when larger cohorts of animals are studied. Because of several differences in the mouse models used and in the methods used to measure and report the data, it is less clear how our globin vector compares with the 2.7-kb LCR used in the vector reported by Pawliuk et al.34 A direct comparison of all of these vectors might be useful to determine the minimal elements needed to achieve consistent, therapeutic expression.
Both the level and pattern of expression of ectopic globin transgenes can be affected by both the site of integration (stable position effect)47 and the probability of expression at that particular site (variegating position effect).48 In transduced MEL cells, we observed highly variable expression of the oncoretroviral γ-globin vectors that contained the HS40 element. Our data suggested the presence of both variegating and stable position effects, in agreement with the variable expression recently reported by others using a similar HS40-based γ-globin oncoretroviral vector.49 In contrast, replacement of the HS40 element with the HS432 configuration in the context of a lentiviral system, which facilitated efficient vector production, resulted in a much higher probability of γ-globin expression. This likely reflects differences in the relative “enhancer” strengths of these 2 sets of regulatory elements, because strong enhancers may ameliorate position effects to some degree.50,51 Consistent with this idea are transgenic mouse studies suggesting that the HS40 element, unlike elements from the β-globin LCR,23 does not function to confer copy-number dependence of ectopic transgene expression.52 Thus, HS40-based vectors appear to lack sufficient transcriptional strength to direct therapeutic globin expression levels.
Despite the overall superior performance of the LCR-based γ-globin lentiviral vector in the MEL cell assay, susceptibility to position effects in vivo was still observed (Figures 4A, 7). We believe this is due to the absence in our vector of additional sequences present in the intact LCR, such as those flanking the HS sites, which provide synergistic enhancement of expression.53 Additionally, even β-globin transgenes up to 150 kb in size and containing the entire β-globin locus are susceptible to variegating position effects.49 Given that the genomic DNA of erythroid cells undergoes widespread heterochromatinization during terminal differentiation, it is not unexpected that a globin gene vector integrated at an ectopic site and lacking an intact LCR shows significant position effects. Indeed, Pawliuk et al reported a significant position effect on expression of their antisickling β-globin lentiviral vector.34 Similar to our findings, multiple vector copies were required to achieve consistent therapeutic expression in that study. May et al did not report an analysis of the impact of position effects on their vector.33 It will be important to evaluate whether inclusion of genetic insulator elements, such as the chicken HS4 element, in globin lentiviral vectors will diminish detrimental position effects similar to that observed when this element has been used in the setting of oncoretroviral vectors.49 54
The use of a γ-globin vector to increase levels of HbF, rather than vectors encoding β-globin or an artificial, antisickling β-globin, offers an alternative therapeutic approach for gene therapy of β-thalassemia and sickle cell anemia. Although it remains to be determined whether γ-globin oncoretroviral vectors lacking LCR elements will be able to provide therapeutic expression levels in appropriate animal models,30,49 this approach has merit given the extensive track record of this vector system in human clinical trials. Alternatively, several laboratories have now shown that lentiviral vectors, with their unique capacity to efficiently transmit complex, LCR element–containing globin expression cassettes, can achieve therapeutic levels of globin expression in preclinical models. It is likely that advances in the design of vector system components to improve the safety profile of lentiviral vectors along with the development of appropriate assays to verify the absence of replication competent lentivirus will eventually result in the use of this promising vector system in the clinic. In regard to the former, our γ-globin vector, unlike those described thus far,33 34 is novel in that it is of self-inactivating design, greatly diminishing the transcriptional potential of the 5′ LTR after proviral integration. This safety feature diminishes the capacity for potential vector mobilization in the host that underwent transplantation. With continued optimization of vector safety and modifications to yield consistent expression of globin cassettes, therapeutic success in humans seems a likely possibility in the future.
We thank the flow cytometry laboratory of Dr Richard Ashmun for expertise in FACS analysis.
Prepublished online as Blood First Edition Paper, October 31, 2002; DOI 10.1182/blood-2002-07-2211.
Supported in part by National Heart, Lung, and Blood Institute (NHLBI) grant KO8 HL04205 (D.A.P.), NHLBI Program Project PO1 HL53749, and Cancer Center Support (CORE) Grant CA-21765 (A.W.N.); and the American Lebanese Syrian Associated Charities.
The publication costs of this article were defrayed in part by page charge payment. Therefore, and solely to indicate this fact, this article is hereby marked “advertisement” in accordance with 18 U.S.C. section 1734.
References
Author notes
Derek A. Persons, 332 N Lauderdale Dr, St Jude Children's Research Hospital, Memphis, TN 38105; e-mail:derek.persons@stjude.org.